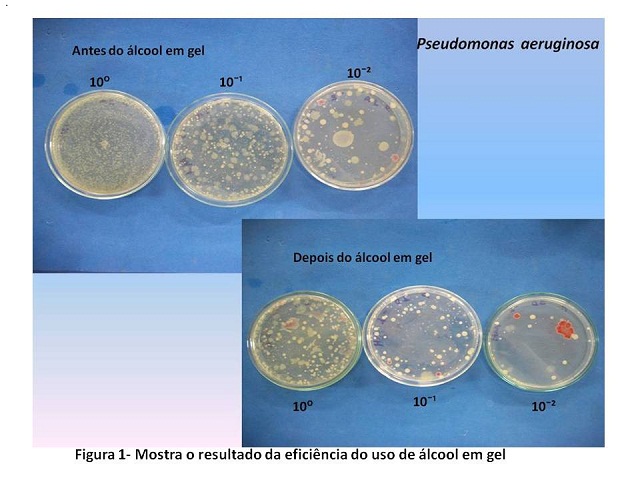

ÁREA: Bioquímica e Biotecnologia
TÍTULO: ANÁLISE DA EFICÁCIA DO ÁLCOOL EM GEL NA REMOÇÃO DE PSEUDOMONAS AERUGINOSA APLICADA ARTIFICIALMENTE NAS MÃOS
AUTORES: MORAIS, G. L. A. (UFPE) ; MOREIRA, A. R. S. (UFPE) ; AMORIM, V. P. P. (UFPE) ; CARDOSO, B.A. (IFPE) ; ALBUQUERQUE, S. S. M. C. (UFPE) ; PALHA, M. A. P. F. (UFPE)
RESUMO: O uso do álcool em gel como procedimento de anti-sepsia das mãos teve um aumento considerável nos últimos anos devido à grande divulgação por parte dos órgãos governamentais. Dessa forma, este estudo teve como objetivo analisar a eficácia de cinco marcas de álcool em gel facilmente encontradas no mercado contra a Pseudomonas aeruginosa, uma bactéria resistente, responsável por uma grande parte das infecções hospitalares. Dentre as cinco marcas avaliadas, pôde-se observar que nenhuma é 100% eficiente na eliminação das bactérias em estudo. Assim, concluiu-se que é indispensável a lavagem das mãos com sabão e água corrente para uma melhor higienização, sendo o álcool em gel um instrumento auxiliar para a higienização das mãos.
PALAVRAS CHAVES: álcool em gel, pseudomonas aeruginosa, mãos
INTRODUÇÃO: Em 2009 houve uma pandemia provocada pelo Vírus da Gripe A (H1N1) e, atualmente, em pleno verão europeu, em vários países, especialmente a Alemanha, tem havido problemas de saúde causados por uma linhagem especial de Escherichia coli , resultado da má higienização de alimentos frescos e pessoal. Por conta do Gripe A, os órgãos governamentais estimularam a população ao uso de Álcool em gel como forma de higienização prática e eficiente, muitas vezes confundida pelo usuário como a única eficiente, no entanto a eficiência desse método é questionável, principalmente para bactérias resistentes, uma vez que vem se registrando uma pressão seletiva dos micro-organismos causada, principalmente, pelo uso indiscriminado de antibióticos, resultando no desenvolvimento de espécies resistentes, entre elas algumas Pseudomonas aeruginosa, considerada agente de risco biológico 2, isto é, capaz de causar doenças em seres humanos e animais apesar de geralmente não apresentar perigo sério a manipuladores e ao ambiente (HIRATA & MANCINI FILHO, 2002). Estas bactérias são Gram-negativas, em forma de bastonetes, aeróbias estritas e que crescem a uma temperatura ótima de 35o - 37oC; produzem pigmentos (piocianina e flurosceína) solúveis que fluorescem quando iluminados por luz ultravioleta, podem sintetizar uma grande variedade de enzimas diferentes que contribuem significativamente para a decomposição de substâncias químicas (FREITAS & BARTH, 2004) e sua resistência. Como a Pseudomonas freqüentemente acompanha a flora contaminante de águas e hortaliças, torna-se necessário pesquisar a eficiência do álcool em gel sobre esse micro-organismo.
MATERIAL E MÉTODOS: 1ª ETAPA (Pesquisa da Pseudomonas aeruginosa): A pesquisa foi fundamentada no Standard Methods for the Examination of Wather and Wastewater (1998), técnica dos tubos múltiplos, onde foi utilizada uma amostra de água sabidamente contaminada. A bactéria Pseudomonas aeruginosa foi identificada utilizando-se tubos contendo meio Asparagina e incubada em estufa a 35°C ± 0,5°C durante 48 horas. Dos tubos turvados considerados positivos foram transferidos uma alíquota do meio de Asparagina para o de Acetamida para a confirmação e após a inoculação foram incubados em estufa a 35°C ± 0,5°C por 48 horas.
2ª ETAPA (Contaminação artificial das mãos): Após o isolamento, foram retirados 0,5 mL do meio de Asparagina e colocado na mão dos voluntários e espalhado por toda palma das mãos durante cerca de 15 segundos.
3ª ETAPA (Inoculação dos swabs): Após a contaminação artificial das mãos, um swab estéril foi umedecido com 1,5 mL de Solução Salina Peptonada(SSP), em seguida foi passado por toda a palma da mão dos voluntários e colocado em um tubo com 10 mL de SSP. Depois, gotejou-se o álcool em gel que foi espalhado por toda a palma das mãos e recolheu-se, através de outro swab estéril e já umedecido, amostras para análise de eficiência, colocando-o em outro tubo com 10mL de SSP. . Foram utilizadas cinco marcas diferentes de álcool em gel facilmente encontradas no mercado e para cada uma destas realizou-se o mesmo processo descrito acima. As marcas foram identificadas por números de 1 a 5.
4ª ETAPA (Inoculação em placas de Petri): Após a inoculação dos swabs, foram realizadas diluições das amostras até 10-2. E estas foram inoculadas em triplicata em placas de Petri contendo o meio de cultura Mueller Hinton Agar e incubadas em estufa a 35°C por 48 horas.
RESULTADOS E DISCUSSÃO: Dentre as cinco marcas de álcool em gel avaliadas, pode-se observar que nenhuma é 100% eficaz na eliminação das bactérias Pseudomonas aeruginosa. Dessa forma, é indispensável a lavagem das mãos com sabão e água corrente para a total eliminação de qualquer patógeno, sendo o álcool em gel um instrumento auxiliar para a higienização das mãos. Para a obtenção dos resultados utilizou-se o processo de Contagem de Unidades Formadoras de Colônias (UFC) por ml para as amostras líquidas em todas as placas inoculadas, desde a amostra original (100) às diluições 10-1 e 10-2, fazendo-se uma média aritmética entre os resultados de cada triplicata. Dessa forma, a marca 1 mostrou-se a mais eficiente ao compará-la às demais, como pode ser observado na Tabela 1 e Figura 1.

CONCLUSÕES: Pôde-se concluir que o uso do álcool em gel não pode ser associado à única forma de higienização prática e eficiente das mãos dispensando o uso de sabão e água corrente, pois a eficácia das 5 marcas estudas mostrou-se reduzida para a Pseuseudomonas aeruginosa , bactéria com histórico de resistência. A legislação brasileira, por meio da Portaria n. 2.616, de 12 de maio de 1998, estabelece que a lavagem das mãos é, isoladamente, a ação mais importante para a prevenção e controle das infecções hospitalares.
AGRADECIMENTOS: A Maria da Conceição Andrade Silva do Laboratório de Microbiologia Industrial e Processos Biotecnológicos do DEQ – UFPE.
REFERÊNCIAS BIBLIOGRÁFICA: BRASIL. Ministério da Saúde. Agência Nacional de Vigilância Sanitária. Resolução nº. 481, de 23 de setembro de 1999. Estabelece os parâmetros de controle microbiológico para os produtos de higiene pessoal, cosméticos e perfumes conforme o anexo desta resolução. Diário Oficial [da União da República Federativa do Brasil], Brasília, DF, 27 set.1999.
BRASIL. Ministério da saúde. Portaria nº. 518, de 25 de março de 2004. Estabelece os procedimentos e responsabilidades relativas ao controle e vigilância da qualidade da água para consumo humano e seu padrão de potabilidade, e dá outras providencias. Diário Oficial [da União da República Federativa do Brasil], Brasília, 26 mar. 2004.
BRASIL. Ministério da Saúde. Portaria nº. 2.616, de 12 de maio de 1998. Estabelece diretrizes e normas para a prevenção e o controle das infecções hospitalares. Diário Oficial [da União da República Federativa do Brasil], Brasília, DF, 13 maio. 1998.
Freitas, A. and A.L. Barth, 2004. Typing of P. aeruginosa from hospitalized patients. Comparison of susceptibility and biochemical profiles with genotypes. Braz. J. Med. Biol. Res., 37: 77-82.
HUGONNET S.; PITTET, D. Hand hygiene – Beliefs or Science? Clinical Microbiology and Infection, v.6, p.348-354, 2000.
MURRAY, P. R.; BARON, E. J.; JORGENSEN, J. H.; PFALLER, M. A.; YOLKEN, R. H. Manual of Clinical Microbiology. 8a ed. Washington: ASM Press, 2004, 1212p
ASSOCIATION FOR PROFESSIONALS IN INFECTION CONTROL AND EPIDEMIOLOGY – APIC. Infection control and applied epidemiology principles and practice. In: RUSSEL, N.O. Mosby Year Book, 1996, 173-186.
ROTTER, M.L. Hand Washing and hand disinfection. In: MAYALL, C.G., Hospital Epidemiology and Infection Control. Philadelphia: Lippincott, 1999, p. 1339-1355.
STANDARD METHODS FOR THE EXAMINATION OF WATER AND WASTEWATER. 20 ed. Washington: American Public Health Association, 1998. 1220p.
TORTORA, G.J.; FUNKE, B.R.; CASE, C.S. Microbiologia. 6. ed. Porto Alegre: Artes Médicas Sul, p. 827, 2000.
Online. Disponível em:
<http://www.anvisa.gov.br/servicosaude/manuais/paciente_hig_maos.pdf >. Acessado em 08/07/2011 às 16:20
